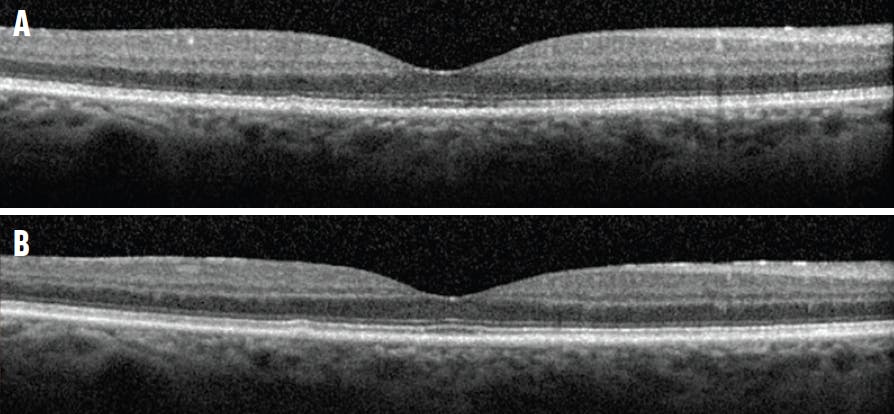
<p>Figure 1. OCT imaging of mild TPSS demonstrates mild blurring of the IS/OS and ELM at presentation (A) and improvement after 1 month (B).</p>
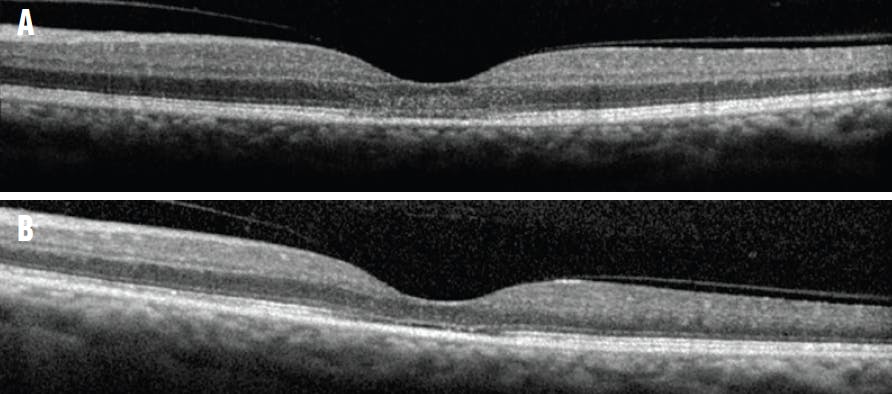
<p>Figure 3. OCT imaging of severe TPSS demonstrates diffuse loss of the outer nuclear layer, IS/OS, ELM, and RPE at presentation (A) and improvement of the IS/OS and persistent disruption of the ELM after 3 months (B).</p>

Dropless cataract surgery, which has become increasingly popular over the past 10 years, involves the administration of intraocular and/or periocular injections of antibiotics and/or steroids at the time of surgery to eliminate the need for postoperative drops.1 Multiple large studies have demonstrated decreased rates of postoperative endophthalmitis after prophylactic intraocular antibiotics at the conclusion of cataract surgery. However, the AAO does not recommend any specific agent or mode of delivery for endophthalmitis prophylaxis.2-5
The study discussed here is the largest case series to date (49 patients [50 eyes]) of retinal toxicity from a specific compounded formulation of triamcinolone-moxifloxacin. Patients were referred to Texas Retina Associates in Dallas after cataract surgery and were identified by query of the EMR system up to 24 months following initial presentation to the practice. Here, we describe the clinical presentation, course, and outcomes from this outbreak of toxic posterior segment syndrome (TPSS).
STUDY RESULTS
Characteristic findings of TPSS include unremarkable postoperative day 1 examination; delayed-onset of painless central vision loss within 1 week, often followed by continued deterioration of central vision for 1 to 2 months; varying degrees of subfoveal blurring and disruption of the outer retinal layers on OCT; reduced rod and cone responses on electroretinogram; and varying degrees of optic disc pallor.
All study eyes were treated with topical corticosteroid drops, and 40 patients were also treated with oral corticosteroids. One eye that did not receive systemic corticosteroids was treated with a single intravitreal anti-VEGF injection for cystoid macular edema (CME).
Patients were referred to our practice 14 to 35 days after cataract surgery. The follow-up period ranged from 1 month to 24 months. Average age at presentation was 64.7 years old (median 66), with an approximately equal gender distribution.
The majority of patients noted blurred vision at postoperative day 1 (n = 41) and photopsia in the affected eye (n = 47). Every patient complained of nyctalopia. Seven eyes had subjectively excellent or improved vision over the first 3 to 7 days, followed by a decline.
TPSS was graded as mild (n = 14), moderate (n = 14), or severe (n = 22) based on the final visual outcome and typical clinical findings. The mean VA at presentation was 20/70 (range 20/25 to 20/400), with a final mean VA of 20/200 (range 20/25 to hand motion).
Mild cases presented with a mean BCVA of 20/41 (range 20/25 to 20/70) and a final mean of 20/37 (range 20/25 to 20/50). Moderate cases had an initial mean BCVA of 20/41 (range 20/25 to 20/400) and a final mean BCVA of 20/77 (range 20/60 to 20/100). Severe cases presented with a mean BCVA of 20/88 (range 20/40 to 20/300) and a final mean BCVA of 20/1025 (range 20/200 to hand motion).
Imaging
Varying degrees of outer retinal thinning on OCT were identified in eyes with TPSS. Every case demonstrated disruption or loss of the external limiting membrane (ELM) and inner segment/outer segment (IS/OS), with greater loss typically correlating with worse TPSS grade and visual acuity (Figure 1). Outer retinal disruption improved gradually over time in each patient (Figure 2). Disruption of the retinal pigment epithelium (RPE) was variable but was typically associated with more severe retinal thinning and worse visual outcomes (Figure 3). Twenty-eight eyes demonstrated involvement of the RPE, with the majority experiencing a final BCVA of 20/200 or worse (n = 21). Only one case of mild TPSS involved the RPE with a final BCVA 20/40.
Figure 1. OCT imaging of mild TPSS demonstrates mild blurring of the IS/OS and ELM at presentation (A) and improvement after 1 month (B).

Figure 2. OCT imaging of moderate TPSS demonstrates blurring and focal loss of the IS/OS and ELM at presentation (A) and improvement after 3 months (B).
Figure 3. OCT imaging of severe TPSS demonstrates diffuse loss of the outer nuclear layer, IS/OS, ELM, and RPE at presentation (A) and improvement of the IS/OS and persistent disruption of the ELM after 3 months (B).
Twelve eyes presented with both anterior chamber inflammation and vitritis. Four eyes had anterior chamber inflammation alone and four eyes had only vitritis. Six eyes had CME, two of which also had concomitant anterior chamber inflammation and vitritis. On fluorescein angiography (FA), 28 eyes were unremarkable with a final BCVA better than 20/200 (mean 20/53). In the remaining 22 eyes, there was evidence of either disc staining (n = 11) or disc leakage (n = 11), with each eye demonstrating a final BCVA of 20/200 or worse (mean 20/1025). Each of the 22 eyes with a final BCVA 20/200 or worse demonstrated a subjectively enlarged foveal avascular zone on FA.
DISCUSSION
TPSS is a rare, visually debilitating condition that can develop after an intraocular injection of compounded triamcinolone-moxifloxacin during cataract surgery. The disease course and findings suggest that TPSS is a progressive toxic maculopathy.
Presentation of this maculopathy occurs with varying onset and a spectrum of effects. Most patients presented with painless vision loss within the first few weeks after cataract surgery that continued to decline for 3 months, after which BCVA appeared to plateau. Each patient noted subjective changes, such as nyctalopia or photopsia, and demonstrated varying degrees of subfoveal outer retinal disruption on OCT. In those who underwent electrophysiologic studies, multifocal electroretinogram demonstrated reduced foveal and parafoveal response that typically continued to decline through 3 months.
FDA Investigation
On July 28, 2017, the FDA released a statement alerting health care professionals to the adverse events associated with a locally compounded intraocular triamcinolone-moxifloxacin from Guardian Pharmacy Services in Dallas. At that time, at least 43 patients who underwent cataract surgery were known to be affected by the product. Over the course of several months, patients had reported various ocular symptoms, such as decreased vision, nyctalopia, decreased color perception, photophobia, glare, and halos.
The FDA launched an investigation into the cause of the adverse events, and multiple samples, including those beyond the expiration date, were tested.
In addition to triamcinolone and moxifloxacin, the product that patients in this study received also contained high concentrations of poloxamer 407, which is often used as a solubilizing and stabilizing agent because of its hydrophilic nonionic surfactant properties. No FDA-approved products intended for intraocular injection contain poloxamer 407, although it is an ingredient in some FDA-approved topical ophthalmic medications. Other poloxamers have been used in FDA-approved intraocular products, and the maximum concentration of poloxamers is 0.1% to 0.2% (g/100 mL);6 the concentration of poloxamer 407 in the study drug was 12% (g/100 mL).
Ultrasonic energy (sonication) is sometimes applied to compounded drugs to help form a homogenous solution. Sonication can induce free radical formation and degrade poloxamers into various organic acids, alcohols, and aldehydes.7 Of note, sonication of poloxamer 407 at concentrations ≥ 5% results in toxic degradation products, including formaldehyde acetaldehyde and formate. Degradation of poloxamer 407 after sonication has been reported to cause cytotoxicity in mammalian cells.7 Poloxamer concentrations above 5% also form bioadhesive gels when exposed to body temperature, resulting in gel expansion and a depot effect of the gel wherever it adheres within the ocular space after injection.7 The intravitreal injection of this formulation in patients lying supine for cataract surgery likely resulted in the accumulation of a toxic depot of bioadhesive gel on the macula.
The FDA analyzed the compounded product, labeled as preservative-free, and identified several other compounds at various concentrations, including the following:
- Methylparaben (0.317 mg/mL) and propylparaben (0.175 mg/mL), substances commonly used as preservatives
- Formaldehyde (0.70 mM)
- Acetaldehyde (0.63 mM)
- Formate (0.49 mM)
- Acetone (0.06 mM)
- 2,2’-methylenebis(6-tert-butyl-4-methylphenol) (0.0361 mg/mL), a substance commonly used in rubber products6
The toxic degradation byproducts of poloxamer 407 (formaldehyde, acetaldehyde, formate, and acetone) were the most likely causes of retinal toxicity in these patients. The surgeons did not inject a uniform amount in each patient, suggesting a dose-dependent toxicity response.
RECOMMENDATIONS
Patients in this case series were treated with topical and systemic steroids, but there was no clear pattern of evidence that any specific treatment alleviated the toxic effects of TPSS. Surgeons and pharmacists should be aware of the drug compounding process for the products they use with their patients. Compounding pharmacies should consider whether their process may generate toxic byproducts and degradants, particularly when intended for intraocular use. Because the FDA does not oversee the quality, safety, or efficacy of these compounded drugs, providers should always inquire about the process and standards employed by the compounding pharmacies prior to use in patients.
1. Chang DF, Braga-Mele R, Henderson BA, Mamalis N, Vasavada A; ASCRS Cataract Committee. Antibiotic prophylaxis of postoperative endophthalmitis after cataract surgery: results of the 2014 ASCRS member survey. J Cataract Refract Surg. 2015;41(6):1300-1305.
2. European Society of Cataract & Refractive Surgeons Endophthalmitis Study Group. Prophylaxis of postoperative endophthalmitis following cataract surgery: results of the ESCRS multicenter study and identification of risk factors. J Cataract Refract Surg. 2007;33(6):978-988.
3. Haripriya A, Chang DF, Ravindran RD. Endophthalmitis reduction with intracameral moxifloxacin prophylaxis: analysis of 600,000 surgeries. Ophthalmology. 2017;124(6):768-775.
4. Olson RJ, Braga-Mele R, Chen SH, et al. Cataract in the adult eye preferred practice pattern. Ophthalmology. 2017;124(2):1-119.
5. Melega MV, Alves M, Lira RPC. Safety and efficacy of intracameral moxifloxacin for prevention of post-cataract endophthalmitis: randomized controlled clinical trial. J Cataract Refract Surg. 2019;45(3):343-350.
6. United States Food and Drug Administration. FDA’s investigation into Guardian’s compounded triamcinolone-moxifloxacin drug product. Accessed August 30, 2022. www.fda.gov/drugs/human-drug-compounding/fdas-investigation-guardians-compounded-triamcinolone-moxifloxacin-drug-product
7. Wang R, Hughes T, Beck S, et al. Generation of toxic degradation products by sonication of Pluronic dispersants: implications for nanotoxicity testing. Nanotoxicology. 2013;7(7):1272-1281.
































